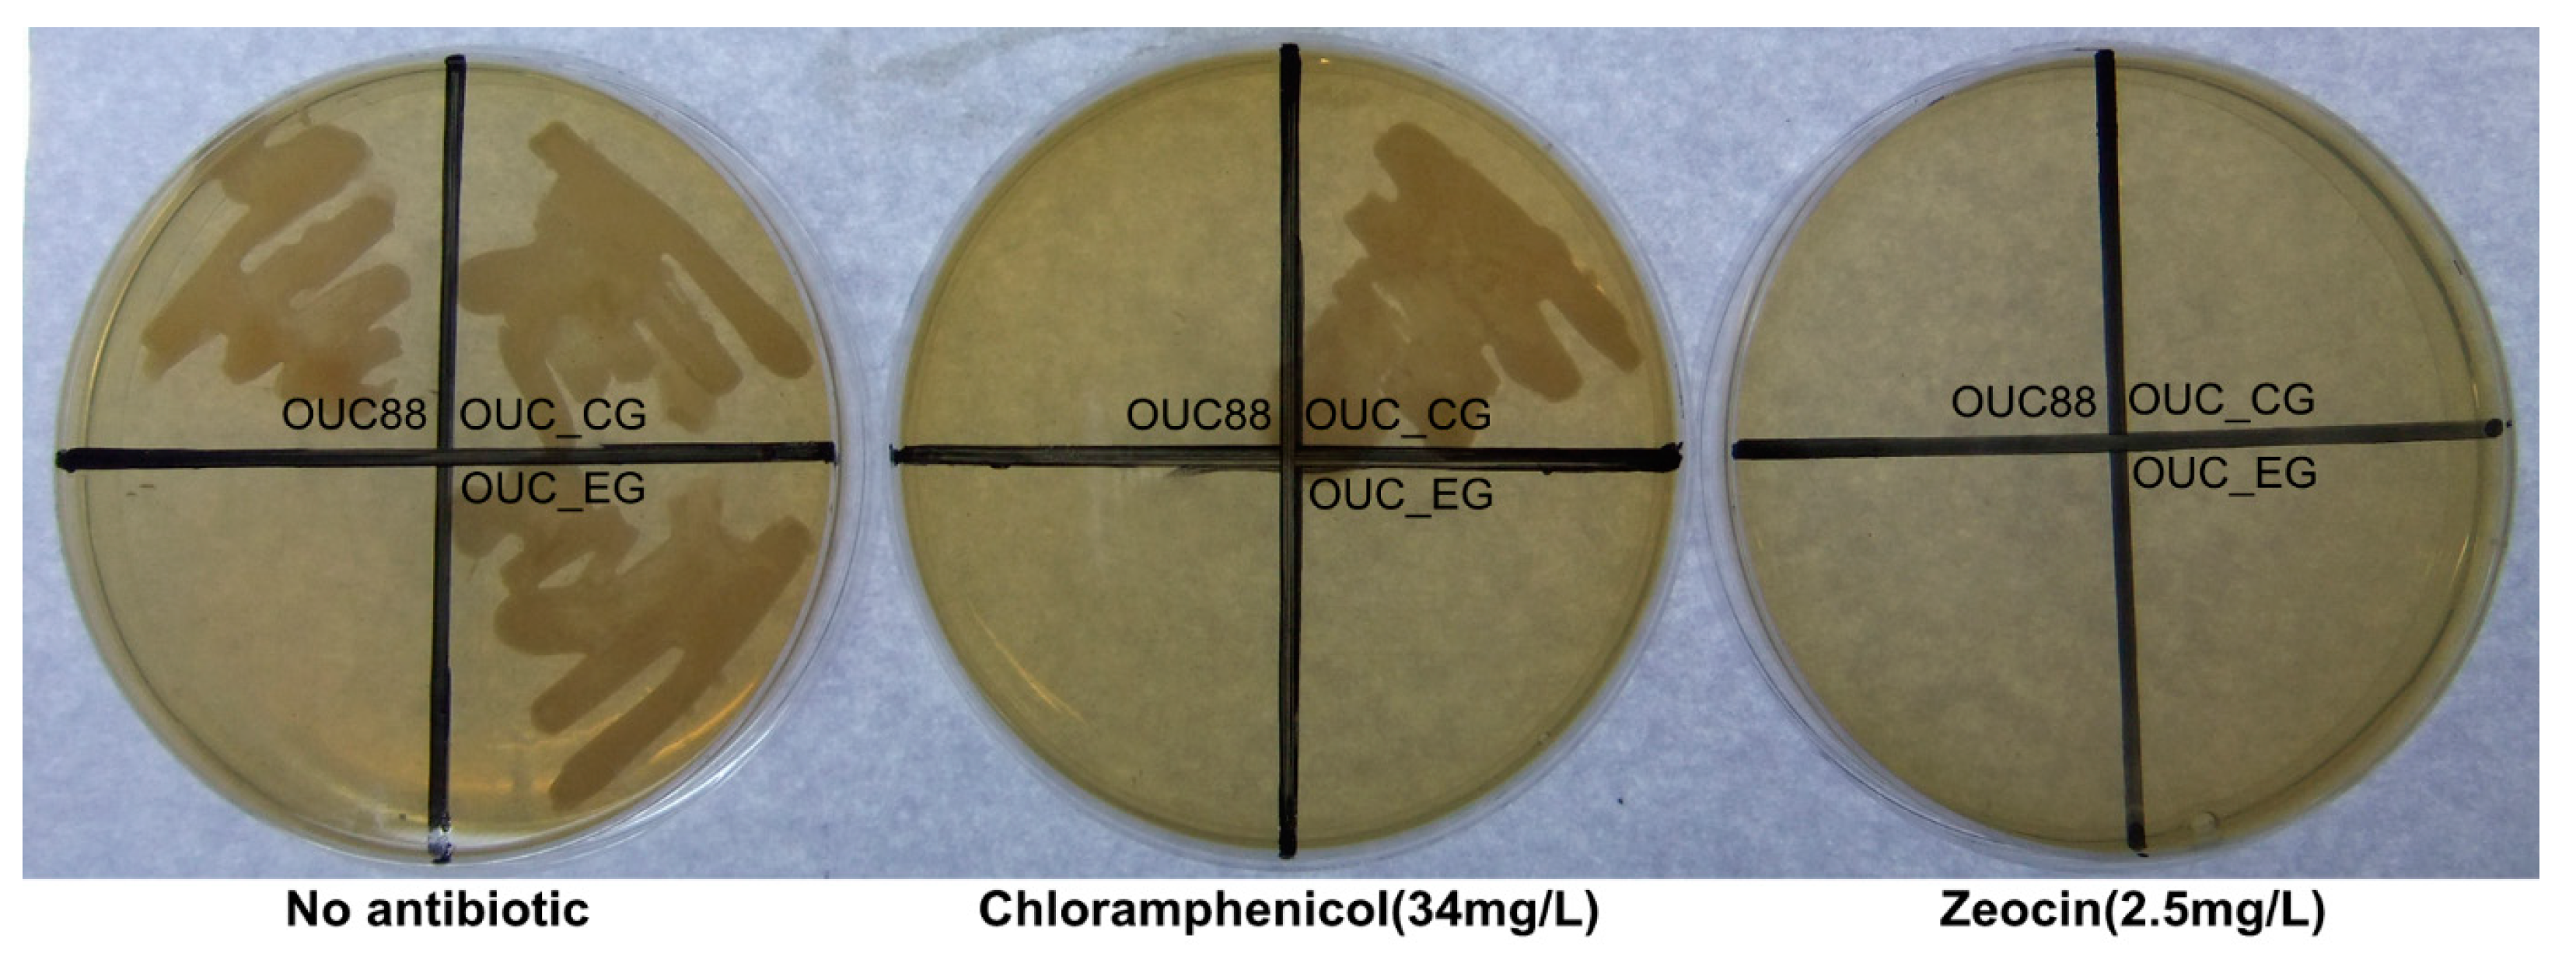
Molecules 20 10110 g003 550

Application of the Cre/loxP Site-Specific Recombination System for Gene Transformation in Aurantiochytrium limacinum
Abstract
:1. Introduction
2. Results and Discussion
2.1. Construction of plasmid p18SCPGC

2.2. Screening of the Transformant after the First Electrotransformation Step
2.3. Screening of the Transformant in the Second Electrotransformation Step

2.4. Hybridization Detection in Southern Blotting

2.5. Fluorescence Detection of Recombinants


3. Experimental Section
3.1. Strains and Media
3.2. Plasmids
3.3. Construction of the Plasmid p18SCPGC
| Primers | Sequence (from 5ʹ to 3ʹ) | Template | Product | Length (bp) |
|---|---|---|---|---|
| Cm-F | ATGGAGAAAAAAATCACTGGAT | Plasmid pACYCDuet-1 | Cmr | 660 |
| Cm-R | TTACGCCCCGCCCTGCCACTCA | |||
| pTUAH-F | CACGTCCGACGGCGGCCCGAC | Plasmid pTUAH | pTUAH | 4168 |
| pTUAH-R | GGTTTAGTTCCTCACCTTGTCG | |||
| EGFP-F | CGCGGATCCATGGTGAGCAAGGGCGAGGA | Plasmid pEGFP-1 | egfp | 720 |
| EGFP-R | TGCTCTAGATTACTTGTACAGCTCGTCCA | |||
| loxP-F | CGAGCTCCTGCTAACATCAAAAGGCCT | Plasmid pUCMU | loxP-Cmr-loxP | 1536 |
| loxP-R | CCGGAATTCATCTTGACTGATTTTTCCATGG | |||
| 18S+-F | GCGGGGCCCGTAGTGTACTGGACTACGGTG | Genomic DNA of different transformants | 18S+-loxP-Cmr-loxP-Ppgk | 3655 |
| Ppgk-R | CGCGGATCCATATTTGTTGTAAAAAGTAGATAATTAC | 18S+-loxP-loxP-Ppgk | 2185 |
3.4. Electrotransformation
3.5. The Screening of Transformants
3.6. Southern Blotting of the Recombinants
3.7. Fluorescence Detection of the Recombinants
4. Conclusions
Acknowledgments
Author Contributions
Conflicts of Interest
References
- Lippmeier, J.C.; Crawford, K.S.; Owen, C.B.; Rivas, A.A.; Metz, J.G.; Apt, K.E. Characterization of both polyunsaturated fatty acid biosynthetic pathways in Schizochytrium sp. Lipids 2009, 44, 621–630. [Google Scholar] [CrossRef] [PubMed]
- Cheng, R.B.; Lin, X.Z.; Wang, Z.K.; Yang, S.J.; Rong, H.; Ma, Y. Establishment of a transgene expression system for the marine microalga Schizochytrium by 18S rDNA-targeted homologous recombination. World J Microb. Biot. 2011, 27, 737–741. [Google Scholar] [CrossRef]
- Cheng, R.B.; Ma, R.; Li, K.; Rong, H.; Lin, X.Z.; Wang, Z.K.; Yang, S.J.; Ma, Y. Agrobacterium tumefaciens mediated transformation of marine microalgae Schizochytrium. Microbiol. Res. 2012, 167, 179–186. [Google Scholar] [CrossRef] [PubMed]
- Li, Q.; Zang, X.N.; Zhang, X.C.; Song, X.J.; Yang, Q. Cloning and analysis of 18S rDNA gene from Schizochytrium limacinum OUC88 and 10 derived strains. Mar. Sci. 2014, 38, 71–78. [Google Scholar]
- Steinberg, N.; Hamilton, D. Bacteriophage P1 site-specific recombination. II. Recombination between loxP sites. J. Mol. Biol. 1981, 150, 467–486. [Google Scholar] [CrossRef]
- Nafissi, N.; Slavcev, R. Bacteriophage recombination systems and biotechnical applications. Appl. Biochem. Biotechnol. 2014, 98, 2841–2851. [Google Scholar] [CrossRef] [PubMed]
- Guo, F.; Gopaul, D.N.; van Duyne, G.D. Structure of Cre recombinase complexed with DNA in a site-specific recombination synapse. Nature 1997, 389, 40–46. [Google Scholar] [CrossRef] [PubMed]
- Dale, E.C.; Ow, D.W. Intra-and intermolecular site-specific recombination in plant cells mediated by bacteriophage P1 recombinase. Gene 1990, 91, 79–85. [Google Scholar] [CrossRef]
- Vega, J.M.; Yu, W.C.; Han, F.Q.; Kato, A.; Peters, E.M.; Zhang, Z.Y.J.; Birchler, J.A. Agrobacterium-mediated transformation of maize (Zea mays) with Cre-lox site specific recombination cassettes in BIBAC vectors. Plant Mol. Biol. 2008, 66, 587–598. [Google Scholar] [CrossRef] [PubMed]
- Khattri, A.; Nandy, S.; Srivastava, V. Heat-inducible Cre-lox system for marker excision in transgenic rice. J. Biosci. 2011, 36, 37–42. [Google Scholar] [CrossRef] [PubMed]
- Liang, M.T.; Yang, C.P.; Xie, Z.P.; Staehelin, C. Use of the Cre-loxP recombination system as an estimate for Agrobacterium-mediated co-transformation of tobacco leaves. Biotechnol. Lett. 2012, 34, 747–754. [Google Scholar] [CrossRef] [PubMed]
- Zou, X.Q.; Peng, A.H.; Xu, L.Z.; Liu, X.F.; Lei, T.G.; Yao, L.X.; He, Y.R.; Chen, S.C. Efficient auto-excision of a selectable marker gene from transgenic citrus by combining the Cre/loxP system and ipt selection. Plant Cell Rep. 2013, 32, 1601–1613. [Google Scholar] [CrossRef] [PubMed]
- Kume, S.; Katayama, N.; Ichida, K.; Hattori-Ihara, S.; Nagasawa, K.; Yoshizaki, G. Transgene manipulation in rainbow trout using Cre recombinase. Fish. Sci. 2014, 80, 767–773. [Google Scholar] [CrossRef]
- Yu, X.J.; Chi, Z.; Wang, F.; Li, J.; Chi, Z.M.; Madzak, C. Expression of the Acid Protease Gene from Saccharomycopsis fibuligera in the Marine-Derived Yarrowia lipolytica for Both Milk Clotting and Single Cell Protein Production. Appl. Biochem. Biotechnol. 2013, 169, 1993–2003. [Google Scholar] [CrossRef] [PubMed]
- Guldener, U.; Heinisch, J.; Koehler, G.J.; Voss, D.; Hegemann, J.H. A second set of loxP marker cassettes for Cre-mediated multiple gene knockouts in budding yeast. Nucleic Acids Res. 2002, 30, e23. [Google Scholar] [CrossRef]
- Li, Q.; Zang, X.N.; Zhang, X.C.; Xu, Y.; Lu, N. Sensitivities of Schizochytrium limacinum to seven antibiotics. J. Wuhan Univ. Nat. Sci. Ed. 2012, 58, 275–280. [Google Scholar]
- Tian, B.Y.; Xu, Y.; Cai, W.L.; Huang, Q.; Gao, Y.Y.; Li, X. Molecular cloning and overexpression of an endo-β-1,4-xylanase gene from Aspergillus niger in industrial Saccharomyces cerevisiae YS2 strain. Appl. Biochem. Biotechnol. 2013, 170, 320–328. [Google Scholar] [CrossRef] [PubMed]
- Viau, S.; Maire, M.A.; Pasquis, B.; Grégoire, S.; Acar, N.; Bron, A.M.; Bretillon, L.; Creuzot-Garcher, C.P.; Joffre, C. Efficacy of a 2-month dietary supplementation with polyunsaturated fatty acids in dry eye induced by scopolamine in a rat model. Graef. Arch. Clin. Exp. 2009, 247, 1039–1050. [Google Scholar] [CrossRef] [PubMed]
- Diau, G.Y.; Hsieh, A.T.; Sarkadi-Nagy, E.A.; Wijendran, V.; Nathanielsz, P.W.; Brenna, J.T. The influence of long chain polyunsaturate supplementation on docosahexaenoic acid and arachidonic acid in baboon neonate central nervous system. BMC Med. 2005, 3, 11. [Google Scholar] [CrossRef] [PubMed]
- Sun, H.J.; Meng, X.Z.; Han, J.H.; Zhang, Z.; Wang, B.; Bai, X.D.; Zhang, X. Anti-cancer activity of DHA on gastric cancer: An in vitro and in vivo study. Tumor Biol. 2013, 34, 3791–3800. [Google Scholar] [CrossRef] [PubMed]
- Robinson, L.E.; Mazurak, V.C. N-3 Polyunsaturated Fatty Acids: Relationship to Inflammation in Healthy Adults and Adults Exhibiting Features of Metabolic Syndrome. Lipids 2013, 48, 319–332. [Google Scholar] [CrossRef] [PubMed]
- Lorente-Cebrián, S.; Costa, A.G.V.; Navas-Carretero, S.; Zabala, M.; Martínez, J.A.; Moreno-Aliaga, M.J. Role of omega-3 fatty acids in obesity, metabolic syndrome, and cardiovascular diseases: A review of the evidence. J. Physiol. Biochem. 2013, 69, 633–651. [Google Scholar] [CrossRef] [PubMed]
- Cheng, R.B.; Ge, Y.Q.; Yang, B.; Zhong, X.M.; Lin, X.Z.; Huang, Z. Cloning and functional analysis of putative malonyl-CoA: Acyl-carrier protein transacylase gene from the docosahexaenoic acid-producer Schizochytrium sp. TIO1101. World J. Microb. Biot. 2013, 29, 959–967. [Google Scholar] [CrossRef] [PubMed]
- Yan, J.F.; Cheng, R.B.; Lin, X.Z.; You, S.; Li, K.; Rong, H.; Ma, Y. Overexpression of acetyl-CoA synthetase increased the biomass and fatty acid proportion in microalga Schizochytrium. Appl. Microbiol. Biotechnol. 2013, 97, 1933–1939. [Google Scholar] [CrossRef] [PubMed]
- Zhu, L.; Zhang, X.; Chang, L.; Wang, A.; Feng, P.; Han, L. Molecular cloning, prokaryotic expression and promoter analysis of squalene synthase gene from Schizochytrium Limacinum. Appl. Biochem. Microbiol. 2014, 50, 411–419. [Google Scholar] [CrossRef]
- Sample Availability: The strain of A. limacinum OUC88 and all the primers used in this research are available from the authors.
© 2015 by the authors. Licensee MDPI, Basel, Switzerland. This article is an open access article distributed under the terms and conditions of the Creative Commons Attribution license ( http://creativecommons.org/licenses/by/4.0/).
Share and Cite
Sun, H.; Chen, H.; Zang, X.; Hou, P.; Zhou, B.; Liu, Y.; Wu, F.; Cao, X.; Zhang, X. Application of the Cre/loxP Site-Specific Recombination System for Gene Transformation in Aurantiochytrium limacinum. Molecules 2015, 20, 10110-10121. https://doi.org/10.3390/molecules200610110
Sun H, Chen H, Zang X, Hou P, Zhou B, Liu Y, Wu F, Cao X, Zhang X. Application of the Cre/loxP Site-Specific Recombination System for Gene Transformation in Aurantiochytrium limacinum. Molecules. 2015; 20(6):10110-10121. https://doi.org/10.3390/molecules200610110
Chicago/Turabian StyleSun, Hengyi, Hao Chen, Xiaonan Zang, Pan Hou, Bingbing Zhou, Yuantao Liu, Fei Wu, Xiaofei Cao, and Xuecheng Zhang. 2015. "Application of the Cre/loxP Site-Specific Recombination System for Gene Transformation in Aurantiochytrium limacinum" Molecules 20, no. 6: 10110-10121. https://doi.org/10.3390/molecules200610110
APA StyleSun, H., Chen, H., Zang, X., Hou, P., Zhou, B., Liu, Y., Wu, F., Cao, X., & Zhang, X. (2015). Application of the Cre/loxP Site-Specific Recombination System for Gene Transformation in Aurantiochytrium limacinum. Molecules, 20(6), 10110-10121. https://doi.org/10.3390/molecules200610110
